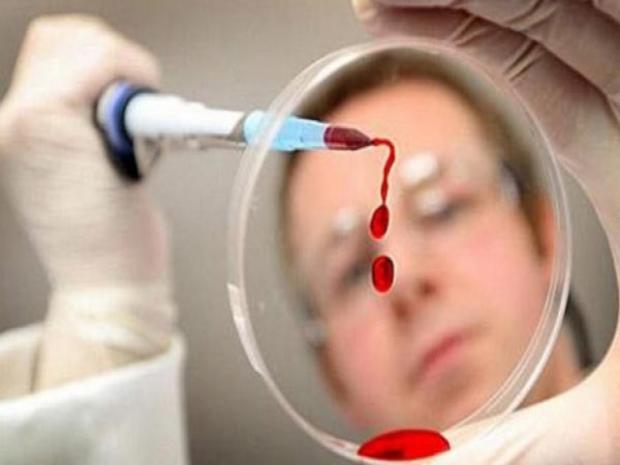
Aids novos casos foram registrados em 2013 em Teixeira (2)

Aids: novos casos foram registrados em 2013 em Teixeira
Os números do Programa Municipal indicam dos 165 novos casos do ano passado, 82 são mulheres e 83 homens
Durante o ano de 2013 foram registrados 165 casos de Aids em Teixeira de Freitas, de acordo com os dados apresentados pelo Centro de Testagem e Aconselhamento (CTA) e o Serviço de Assistência Especializada (SAE).
De acordo com a coordenadora do CTA/SAE de Teixeira de Freitas, Mirileide Lima dos Santos Barbosa, atualmente são 318 soropositivos, incluído todas as regiões atendidas pelo CTA/SAE, que são os municípios de Nova Viçosa, Itanhém, Prado, Caravelas, Lajedão, Ibirapuã, Alcobaça, Vereda, Medeiros Neto e Mucuri.
Os números do Programa Municipal indicam dos 165 novos casos do ano passado, 82 são mulheres e 83 homens.

Mirileide informou ainda o quantitativo de testes feitos no ano passado, sendo 2.047 testes rápidos somente no programa. Ela falou também sobre a facilidade de realizar o teste rápido para diagnosticar o vírus. “O processo é simples, no qual as pessoas assistem a uma palestra de orientação sobre a doença e depois passa por uma triagem e por fim realiza a coleta, sendo que o resultado sai no mesmo dia, o exame para detectar e a medicação são oferecidas pelo SUS”, disse a coordenadora.
Por: Sul Bahia News
